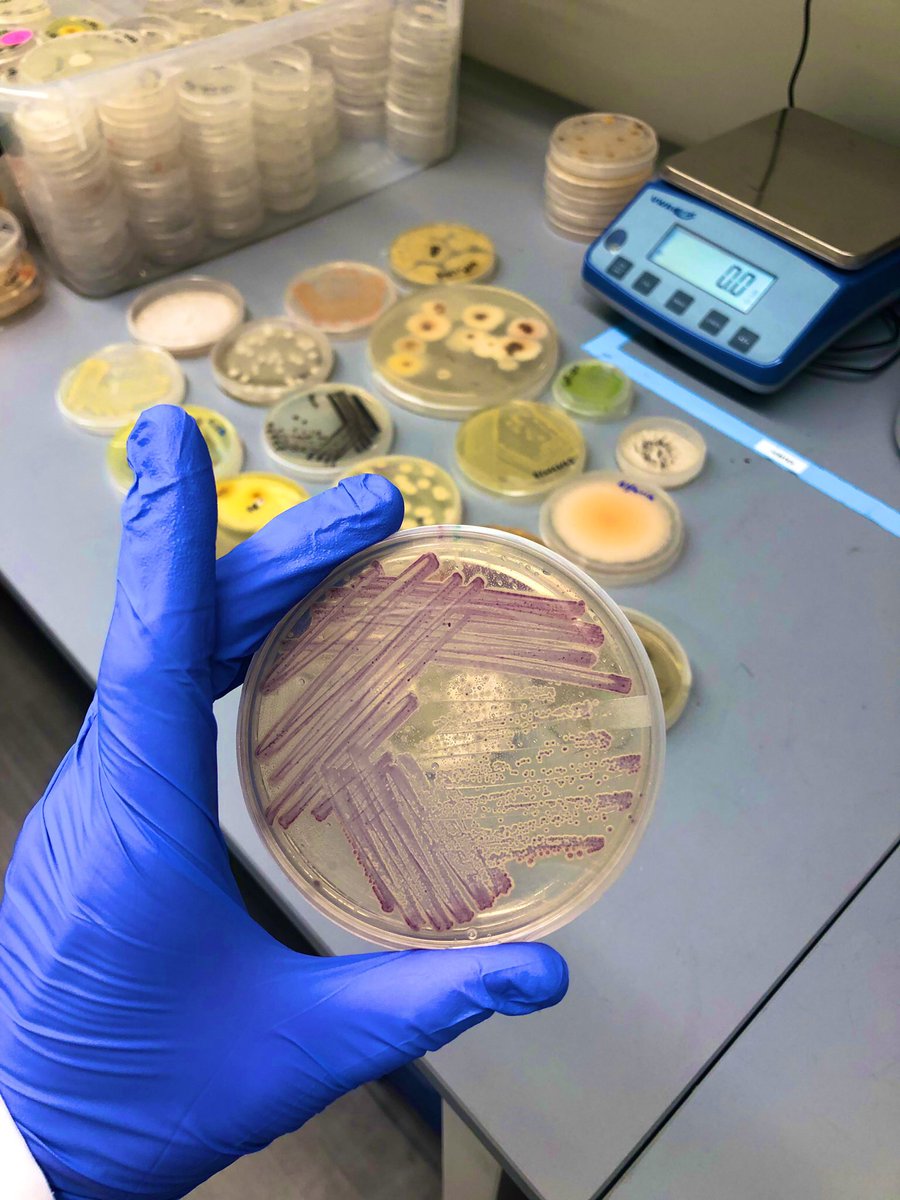
Dr. Anne A Madden tweet media

Sabitlenmiş Tweet

My TED talk on the wonders of our microbial world and the technologies hiding in your dust bunnies.
#TED #Microorganisms #Bacteria #Fungi #SciComm #TEDtalks @TEDTalks
ted.com/talks/anne_mad…

English
Dr. Anne A Madden
9.3K posts

@AnneAMadden
Microbe wrangler, scientist, founder The Microbe Institute. Now on the cerulean atmosphere platform (same handle)

Brooke Jude (@JudeLab_Bard) teamed up with @AnneAMadden of The Microbe Institute and @ATW80Fabrics to harness purple-pigmented microbes for use in sustainable dyeing practices. bit.ly/3U08JnN

